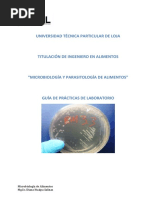

Resolucion 2115 de 2007 (AGUA POTABLE)
PARA E. coli Y COLIFORMES TOTALES: Filtración por membrana, Sustrato Definido, enzima sustrato y presencia - ausencia. Se podrán
adoptar otras técnicas y metodologías debidamente validadas por el Instituto Nacional de Salud - INS - o éste realizará una revalidación con
base en documentos soporte de organismos internacionales que presenten los solicitantes.
COLIFORMES TOTALES Y FECALES / Escherichia coli
Norma Medio METODO/Descripcion Matriz Complementaria
STANDARD METHODS Agar Endo / RECUENTO TOTAL DE COLIFORMESPOR Aguas Para lograr la
Caldo m- EL MÉTODO DE FILTRACIÓN POR identificación total se
Endo MEMBRANA (Copa desechable) necesitan pruebas
bioquímicas:
Indol: Reactivo de Kovacs
(caldo triptofano), prueba
positiva presuntiva E.coli
Agar EMB, TSI, LIA
STANDARD METHODS Colilert sustrato cromogénico como o-nitrofenil- Aguas Indol: Reactivo de Kovacs
-D-galactopiranósido (ONPG), Rojo de (caldo triptofano), prueba
(Sustrato clorofenol--D-galactopiranósido (CPRG positiva presuntiva E.coli
definido) ó X-GAL), Sustrato fluorogénico como
MUG (4-methylumbelliferyl-beta- Agar EMB, TSI, LIA
Dglucuronide)
STANDARD METHODS Caldo Lauril NMP de coliformes totales y fecales Aguas Indol: Reactivo de Kovacs
Triptosa (caldo triptofano), prueba
positiva presuntiva E.coli
Caldo
Lactosa Agar EMB, TSI, LIA
Bilis Verde
Brillante
ISO 9308-1:2014/A1:2017 Calidad del Agar Detección y recuento de Escherichia coli Agua Indol: Reactivo de Kovacs
agua. Recuento de Escherichia coli y de lactosado y bacterias coliformes destinada (caldo triptofano), prueba
bacterias coliformes. Parte 1: Método de con TTC al consumo positiva presuntiva E.coli
filtración por membrana para aguas con humano
bajo contenido de microbiologico. Agar EMB, Agar
MacConkey, TSI, LIA
NTC 4772:2008 CALIDAD DEL AGUA.
DETECCION Y RECUENTO DE ESCHERICHIA COLI
Y DE BACTERIAS COLIFORMES. PARTE 1:
METODO DE FILTRACION POR MEMBRANA
NTC 4558:2007 MICROBIOLOGÍA DE VRBL + Detección y recuento de Escherichia coli Alimentos No describe
ALIMENTOS Y DE ALIMENTOS PARA MUG y bacterias coliformes
ANIMALES. MÉTODO HORIZONTAL PARA
EL RECUENTO DE COLIFORMES O
Escherichia coli O AMBOS. TÉCNICA DE AGAR CON
RECUENTO DE COLONIAS UTILIZANDO TRIPTONA
MEDIOS FLUOROGÉNICOS O BILIS X
CROMOGÉNICOS
� GLUCORINI
DO
AOAC® Official Methods of Analysis Petrifilm™ Detección y recuento de Escherichia coli Alimentos Indol: Reactivo de Kovacs
(OMA) #991.14 para alimentos AOAC® Placas E. y bacterias coliformes (caldo triptofano), prueba
Official Methods of Analysis (OMA) coli / positiva presuntiva E.coli
#998.08 para aves, cárnicos y pescados Coliformes
& mariscos Agar EMB, Agar
MacConkey, TSI, LIA
No descrita Agar EMB Util en el aislamiento de la Familia Muestras Indol: Reactivo de Kovacs
enterobactericiae, de escasos clinicas (caldo triptofano)
requerimientos nutricionales y una
diversidad de bacilos gram-negativos, p. Agar MacConkey, TSI, LIA
ej. Pseudomonas y Aeromonas , no
inhibe completamente los
microorganismos gram-positivos,
tambien crece candida color rosado.
Crece (+): Negro azulado
No descrita Agar Bacilos Gram negativos de facil Muestras Indol: Reactivo de Kovacs
MacConkey desarrollo, aerobios y anaerobios clinicas, (caldo triptofano)
facultativos. aguas y
alimentos. Agar EMB, TSI, LIA
Inhibición entre parcial y completa de
bacterias gram positivas, inhibe hongos Siembra
y levaduras. superficie/
profundida
Crece (+): Rosado- rojizo d
ISO 9308-1:2014/A1:2017 Calidad del Chromocult Permite la detección, enumeración y Aguas Colonias (Escherichia coli
agua. Recuento de Escherichia coli y de coliformes confirmación simultáneas de coliformes ATCC 8739 ) azul oscuro a
bacterias coliformes. Parte 1: Método de y E. coli en agua en 24 hora violeta
filtración por membrana para aguas con
bajo contenido de microbiota. Sustrato cromogenico Rojo de Colonias (Enterobacter
clorofenol--D-galactopiranósido (CPRG aerogenes ATCC 13048)
ó X-GAL) rosa a rojo
No descrita Caldo- m Detección de coliformes totales y de E. Para el No describe.
ColiBlue coli. Las coliformes totales forman análisis del
colonias rojas. E. coli forma colonias agua
azules potable y
el agua
ambiental.
USP: Bacterias gram-negativas resistentes Caldo Deteccion de enterobacterias, Entre las Materias No describe.
a las sales biliares mossel / bacterias Gram negativas resistentes a primas,
las sales biliares se encuentra producto
Agar VRBG Escherichia, Pseudomonas y Aeromonas. en
o VRBL proceso,
producto
terminado.
ISO 21528-1: 2017 y II Microbiología de Agar VRBG Deteccion de enterobacterias Alimentos No describe.
la cadena alimentaria. Método horizontal o VRBL
para la detección y enumeración de productos destinados al consumo
Enterobacteriaceae. Parte 1: Detección de humano y a la alimentación de animales,
Enterobacteriaceae y muestras ambientales en el área de
producción y manipulación de alimentos
ISO 4832: 2006 Microbiología de
alimentos y piensos. Método horizontal
para la enumeración de coliformes.
Técnica de recuento de colonias.
Cepas para análisis: Klebsiella aerogenes ATCC 13048 ( Estudio de coliformes totales) , Citrobacter freundii ATCC 43864
( proporciona brillo metalico o pigmento similar en agar EMB) , Klebsiella oxytoca (indol positivo igual que Escherichia coli)
�Metodo determinacion Bacterias gram-negativas resistentes a las sales biliares
Las enfermedades infecciosas han influido de forma determinante en la evolución de la historia del hombre. Son actualmente
una de las principales causas de mortalidad en el mundo provocando un número considerable de infecciones.
Entre las bacterias Gram negativas resistentes a las sales biliares se encuentra Escherichia, Pseudomonas y Aeromonas.
PREPARACIÓN DE LA MUESTRA
En una concentración 1:10 preparar la muestra usando al menos 1 g del producto a examinar en Caldo Soja Tripticaseína y
homogeneizar. Incubación a 20-25 ºC por 2-5 horas
1) TEST DE AUSENCIA DE ENTEROBACTERIAS Y OTRAS BACTERIAS GRAM NEGATIVAS
1.1 ENRIQUECIMIENTO PRIMARIO
Salvo indicación prescrita, sembrar el volumen correspondiente a un 1 g de producto en 100 ml de Caldo
Mossel . Incubación a 30-35 ºC por 24-48 horas
1.2 AISLAMIENTO SELECTIVO
Realizar subcultivos en placas de Agar Bilis y Rojo Violeta con Glucosa (VRBG) Incubación a 30-35 ºC por 18-
24 horas
1.3 INTERPRETACIÓN DE RESULTADOS
El producto satisface el ensayo si no se observa crecimiento de colonias
2) ENSAYO CUANTITATIVO DE ENTEROBACTERIAS Y OTRAS BACTERIAS GRAM NEGATIVAS
2.1 ENRIQUECIMIENTO PRIMARIO
Preparar tres tubos con diluciones que contengan 0.1 g, 0.01 g y 0.001 g del producto a examinar en 10 ml de de
Caldo EE Mossel Incubación a 30-35 ºC por 24-48 horas.
2.2 AISLAMIENTO SELECTIVO
Realizar subcultivos en placas de Agar Bilis y Rojo Violeta con Glucosa (VRBG). Incubación a 30-35 ºC por 18-24
horas
2.3 INTERPRETACIÓN DE RESULTADOS
El crecimiento de colonias constituye un resultado positivo. Anotar la menor cantidad del producto que da un
resultado positivo y la mayor cantidad que da un resultado negativo. Consultar la tabla de la Farmacopea Europea
Determinacion de Salmonella sp.
Salmonella es una familia de microorganismos muy diversa, que incluye unos 2.300 serotipos distintos. Es una de las cuatro
causas principales de enfermedades diarreicas. Este grupo de bacterias se presenta en forma de bacilo gram-negativo (ya
que pertenecen al enorme grupo de las Enterobacterias), son anaerobias facultativas y móviles mediante flagelos. Además,
son fermentadoras de glucosa pero no de lactosa y no producen ureasa.
PREPARACIÓN DE LA MUESTRA
En una concentración 1:10 preparar la muestra usando al menos 10 g/ 10 ml del producto a examinar en Caldo Soja
Tripticaseína y homogeneizar. Incubación a 30-35 ºC por 18-24 horas. El Caldo de Soja Tripticaseína puede suplementarse
con neutralizantes y surfactantes.
ENRIQUECIMIENTO SELECTIVO Sembrar 0.1 ml del Caldo de Soja Tripticaseína en 10 ml de Caldo Rappaport Vassidialis
(CAT. 1414) Incubación a 30-35 ºC por 18-24 horas (Sugiere la ficha tecnica 41,5±1 ºC favorecer la selectividad, el verde
de malaquita inhibe otros organismos y tiene condiciones osmoticas altas)
AISLAMIENTO SELECTIVO Realizar subcultivos en placas de Agar XLD (Agar Xilosa Lisina Desoxicolato) (CAT. 1080)
Incubación a 30-35 ºC por 18-48 horas
INTERPRETACIÓN DE RESULTADOS Todas las colonias rojas con/sin núcleo negro son suceptibles de ser S almonella.
Confirmación mediantes test de identificación. El producto satisface el ensayo si no se observan colonias de los tipos
descritos o si son negativos los ensayos de confirmación